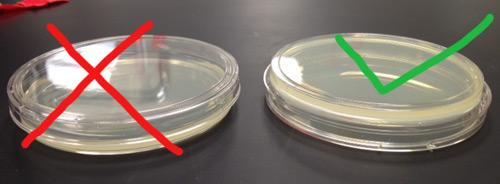
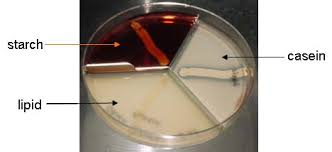
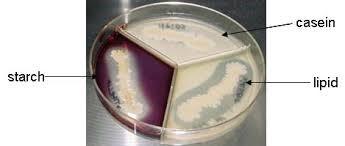

Agar plate orientation

Different medium

What type of tube is this?
Carbohydrate Fermentation tube
Used to determine the ability to ferment carbohydrates (glucose,
lactose, mannitol, sucrose & maltose broths w/ phenol red
indicator)
Results:
acid production = yellow (pH<
7)
gas production = bubble formation in Durham tube
negative fermentation = red/pink no gas & not yellow (pH 5)

Glucose (Carb. test)
Left: Fermentation with acid & gas production (A/G) bubble in
tube
2nd: Fermentation acid without gas (A/-) no bubble in
tube
3rd: control. 4th: No fermentation no reaction (-/-) red no
bubble in tube
5th: degradation of peptone w/alkaline end
products (K) no bubble in tube
IMViC
Methyl red, Voges-Proskauer, Indole and Citrate
used to distinguish between members of the family Enterobacteriasea and differentiate them from other Gram-negative rods

Methyne red
Mixed acid fermentation
Left MR-positive (+) red / mixed acid fermentation
Right MR-negative (-) no color change/ yellow / no mixed acid fermentation

Voges–Proskauer
left VP- negative (-) / copper color at top means reaction of KOH and alfa-naphthol / no color change / no 2, 3 butanediol fermentation (no acetoin produced)
right VP-positive (+) / red / 2, 3 butanediol fermentation (acetoin produced)


Indole
Organism converts tryptophan to indole

Simmons Citrate slants
Left tube: uses citrate (+) blue
Center tube: does not use
citrate (-) no color change
Right tube: control inoculated
Simmons Citrate Agar-used to determine if capable of using citrate as the sole source of carbon w/ production of enzyme citratase.
-Medium contains sodium citrate, ammonium salts & brom thymol
blue (pH indicator)
-Procedure: stab/streak method then incubate
24-48 hrs

Nitrate
Organism reduces NO3 --> NO2

Nitrate. Reagents A+B added. Interpret tubes
Tube 1 (left): red, positive result. Nitrate reduced to
nitrite
Tube 3, 4: inconclusive, no color change. Must add zinc
dust.
Tuble 2: control

Nitrate. +Zinc, interpret tubes 3, 4
Tube 3: red color indicates nitrate is still present. Negative
result. Organism does not reduce nitrate.
Tube 4: no color
change, organism reduced nitrate to some other nitrogenous compound.
Positive result.

Starch Hydrolysis
Top: no clearing, organism does not break down starch.
Bottom: clearing in medium, organism breaks down starch (amylase is present)
Microorganisms excrete hydrolytic extracellular enzymes in order to degrade starch
Glucose
That will be transported into the cell and use for energy production (Glycolysis)

Caesin Hydrolysis test
Casein (proteases)
Organisms producing proteases will show a zone of lipolysis (clear area surrounding the bacterial growth)

Caesin Hydrolysis test
Top: casease-positive (+) present of casease
bottom:
casease-negative (-) absent of casease
...
Lipid Hydrolysis test
Above lipase-positive (+) lipase present / clearing in agar around growth
Below lipase-positive (-) absent of lipase / no clearing in agar around growth
Lipid Hydrolysis test
Lipid ( tributyrin ) (lipases)
Organisms producing lipases will show a zone of lipolysis (clear area surrounding the bacterial growth)

Urea hydrolysis
Left urease-positive
(+) rapid urea splitter hydrolysis; strong urease production
Center uninoculated
control
Right
Urease-negative (-) no urea hydrolysis; urease absent

Gelatin Hydrolysis test
Top: liquid gelatin indicates gelatinase-postive (+) Gelatin is liquid (control is solid) Gelatinase is present in organism
Bottom: solid gelatin indicates gelatinase-negative (-) Gelatin is solid. No gelatinase is present in organism
Organisms producing proteases will show liquefaction of the gelatin, low temperatures of 4°C will not restore the gel characteristic.

SIM MEDIA TEST
SULFUR POSITIVE vs Sulfur NegativeIndole Negative in both(Note: Indole indicator: Kovac)
MOTILITY POSITIVE vs Motility Negative(Note: Motility Indicator: Stabline)

Sulfur reduction in
SIM medium
-when a species can reduce
sulfide there is a black precipitate that forms turning the agar black.
Left No black in the medium / Sulfur is not reduced / H2 S-negative (-)
Right Black in the medium / Sulfur reduced / H2 S-positive (+)

Indole test
Left indole-negative (-) organism Reagent color is unchanged Tryptopha is not broken down into indole ad pyruvate
Right indole-positive (+) organism / Red in the alcohol layer of Kovac's reagent. Tryptopha is broken down into indole ad pyruvate

Motility in SIM
Left motile organism / Growth radiating outward from stab line
Right nonmotile organism / Non radiating growth

Litmus milk Medium